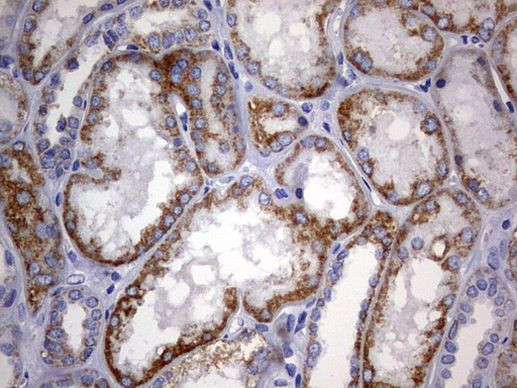
ARL3 Antibody in Immunohistochemistry (Paraffin) (IHC (P))

Search
OriGene
ARL3 Monoclonal Antibody (OTI2A9), TrueMAB™
{{$productOrderCtrl.translations['antibody.pdp.commerceCard.promotion.promotions']}}
{{$productOrderCtrl.translations['antibody.pdp.commerceCard.promotion.viewpromo']}}
{{$productOrderCtrl.translations['antibody.pdp.commerceCard.promotion.promocode']}}: {{promo.promoCode}} {{promo.promoTitle}} {{promo.promoDescription}}. {{$productOrderCtrl.translations['antibody.pdp.commerceCard.promotion.learnmore']}}
产品信息
CF803091
种属反应
宿主/亚型
分类
类型
克隆号
抗原
偶联物
形式
浓度
规格
纯化类型
保存液
内含物
保存条件
运输条件
产品详细信息
For reconstitution, we recommend adding 100 µL distilled water to a final antibody concentration of about 1 mg/mL. To use this carrier-free antibody for conjugation experiments, we strongly recommend performing another round of desalting. (Zeba Spin Desalting Columns, 7KMWCO, 0.5 mL, Product # 89882)
靶标信息
ADP-ribosylation factors (ARFs) are low molecular weight GTP-binding proteins belonging to the RAS superfamily. The predicted 182-amino acid ARL3 (ADP-ribosylation like factor) protein shares 97% amino acid identity with rat ARLl3 and 43% identity with human ARF1. Like the ARFs, ARL3 has a glycine at position 2, the site of N myristoylation, and lacks cysteine residues near the C terminus, which are found in other members of the RAS family. Northern blot analysis detected a 1-kb ARL3 transcript in all tissues tested, with highest expression in heart and lung, and lower expression in brain, liver, kidney, ovary, and testis. A 5.5-kb transcript was also detected in most tissues, with highest expression in brain. Immunoblot analysis detected ARL3 in human tumor cell lines but not in normal rodent cells. Although ARL3 binds GTP, it is devoid of activity in the cholera toxin-dependent ADP-ribosylation of Gs, and is therefore classified as an ARF-like protein.
仅用于科研。不用于诊断过程。未经明确授权不得转售。
篇参考文献 (0)
生物信息学
蛋白别名: ADP ribosylation factor like GTPase 3; ADP-ribosylation factor-like 3; ADP-ribosylation factor-like protein 3; ARF-like 3; Arf-like protein 3; ARL3; small GTP binding protein; unnamed protein product
基因别名: ARFL3; ARL3; JBTS35; RP83
UniProt ID: (Human) P36405
Entrez Gene ID: (Human) 403